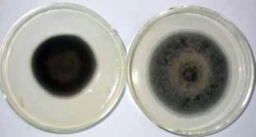

【作者】伏建国 强胜 朱云枝
【机构】南京农业大学杂草研究室 南京农业大学杂草研究室 南京210095
【摘要】以链格孢菌Alternariaalternata菌株NEW为供试菌株,研究了菌龄、酶系统、酶解时间、酶解温度及稳渗剂对链格孢菌原生质体制备的影响。结果表明,制备链格孢菌原生质体比较适宜的条件为PD液体培养基培养20h,以0.7mol/LNaCl为稳渗剂、1%LysingEnzyme、1%Drislase和1%Snailase3种酶溶液混合使用,30℃酶解3h。对原生质体进行了限制性内切酶介导整合(REMI)转化,筛选到了链格孢菌弱致病突变株NEW001,为致病相关基因的标记和克隆打下了基础。
【基金】国家863项目(2001AA246012); 国家自然科学基金(30170619)资助;
Manbetx体育手机版推荐A9版本制备原生质体适宜条件; 致病性变异; 弱致病突变株;


NEW001 和 NEW 致病力比较
突变株 NEW001 和野生型菌株 NEW 菌落形态的比较

NEW001 和 NEW 致病力比较





